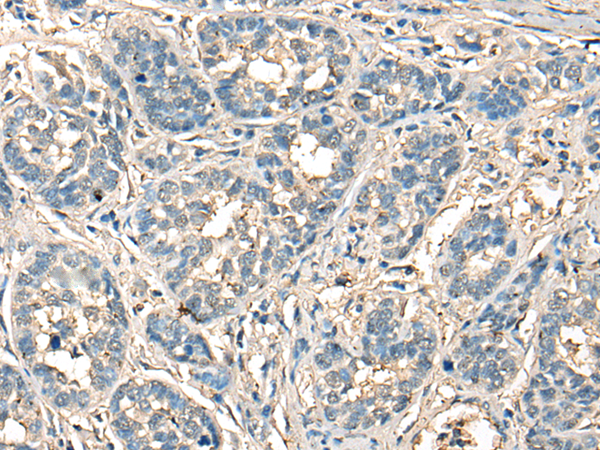

中文名稱:兔抗CELA1多克隆抗體
英文名稱: Anti-CELA1 rabbit polyclonal antibody
別 名:chymotrypsin like elastase family member 1; ELA1
相關(guān)類別: 一抗
抗 原: CELA1
儲(chǔ) 存: 冷凍(-20℃)
宿 主: Rabbit
反應(yīng)種屬: Human, Mouse, Rat
標(biāo) 記 物: Unconjugate
克隆類型: rabbit polyclonal
技術(shù)規(guī)格
|
Background: |
Elastases form a subfamily of serine proteases that hydrolyze many proteins in addition to elastin. Humans have six elastase genes which encode the structurally similar proteins elastase 1, 2, 2A, 2B, 3A, and 3B. Unlike other elastases, pancreatic elastase 1 is not expressed in the pancreas. To date, elastase 1 expression has only been detected in skin keratinocytes. Clinical literature that describes human elastase 1 activity in the pancreas or fecal material is actually referring to chymotrypsin-like elastase family, member 3B. |
|
Applications: |
ELISA, IHC |
|
Name of antibody: |
CELA1 |
|
Immunogen: |
Synthetic peptide of human CELA1 |
|
Full name: |
chymotrypsin like elastase family member 1 |
|
Synonyms: |
ELA1 |
|
SwissProt: |
Q9UNI1 |
|
ELISA Recommended dilution: |
5000-10000 |
|
IHC positive control: |
Human liver cancer and human esophagus cancer |
|
IHC Recommend dilution: |
25-100 |

購物車
購物車 幫助
幫助
 021-54845833/15800441009
021-54845833/15800441009
